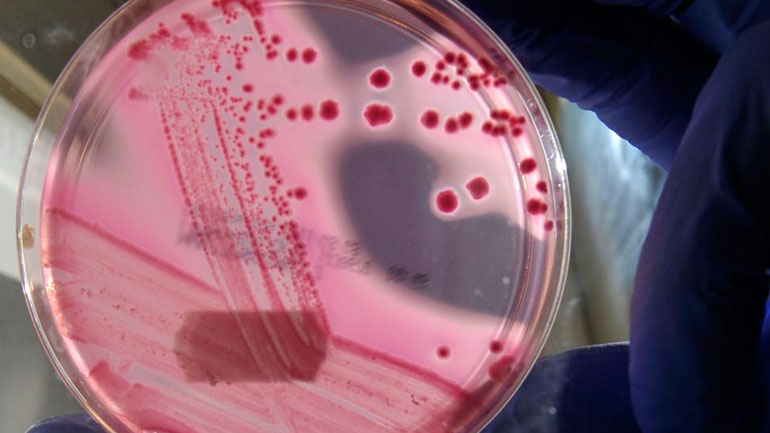
Ο έρπης μπορεί να σταματήσει τον καρκίνο του δέρματος

Διπλάσιος κίνδυνος άνοιας μετά την εκδήλωση του ιού του έρπητα
Στο παρελθόν έχει διεξαχθεί έρευνα για να διερευνηθεί εάν ο ιός του απλού έρπητα θα μπορούσε να είναι ένας πιθανός παράγοντας κινδύνου για άνοια, κάτι που τώρα επιβεβαιώνεται σε αυτή τη μελέτη.
19/02/2024 | 09:43